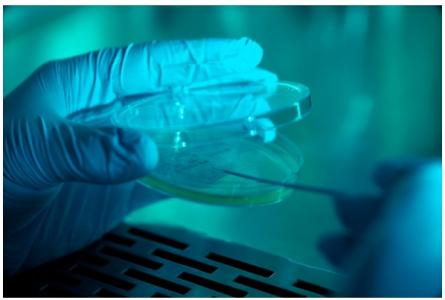
On sait que les ulcères du pied diabétique sont parmi les plaies les plus longues à cicatriser. Ils mettent entre 90 et 150 jours pour guérir.

ULCÈRE DIABÉTIQUE : Des pansements chargés d’oxyde nitrique à libération ajustée
On sait que les ulcères du pied diabétique sont parmi les plaies les plus longues à cicatriser. Ils mettent entre 90 et 150 jours pour guérir. Ces chercheurs de l’Université du Michigan proposent un dispositif qui amplifie ce que le corps fait déjà naturellement : alors que chez les patients diabétiques, la réduction de la production d'oxyde nitrique réduit la capacité de cicatrisation et précisément d’épidermisation, ils développent un pansement chargé d’oxyde nitrique à libération ajustée en fonction des besoins cellulaires. Ce nouveau dispositif présenté dans la revue Medical Sciences, pourrait, semble-t-il, ramener un délai de cicatrisation moyen de 150 jours à 21 jours, ou moins.
Les ulcères du pied diabétique pourraient donc cicatriser 7 fois plus rapidement avec cette nouvelle technologie à base d'oxyde nitrique, et selon ces premières données. Un espoir immense pour les plus de 400 millions de personnes qui vivent avec le diabète et les plus de 15% qui finissent par développer un ulcère du pied, un facteur associé à un risque de décès multiplié par 2,5.
A nouveau, le concept s’inspire d’un processus naturel du corps, la libération d’oxyde nitrique nécessaire à la réparation tissulaire. Or chez les patients diabétiques, une diminution de la production d'oxyde nitrique réduit le pouvoir de guérison des cellules de la peau. Cette réduction des niveaux d'oxyde nitrique contribue à expliquer pourquoi 15% des patients atteints de diabète de type II luttent contre des ulcères du pied chroniques, difficiles à guérir. Mais la solution ne consiste pas seulement à apporter de l'oxyde nitrique, il s’agit aussi d’ajuster sa libération en fonction des conditions cellulaires. Ainsi, l’équipe a d’abord cherché à comprendre ce qui se passe avec l’oxyde nitrique dans les fibroblastes, des cellules de la peau, en particulier en cas de diabète.
La cicatrisation des plaies, une symphonie d'événements complexe à médiation cellulaire : 3 types de cellules de la peau interviennent durant le processus de cicatrisation de la plaie. Les macrophages sont les premiers intervenants, ils arrivent dans les 24 heures qui suivent la blessure. Ensuite, les fibroblastes suivent, tels des « ingénieurs du corps ». Ils vont contribuer à établir la matrice extracellulaire qui va permettre aux cellules suivantes, les kératinocytes, d’arriver et de faire le gros du travail de reconstruction. Mais quand un acte de cette symphonie est déréglé, le processus entier échoue. Les fibroblastes, qui ne sont pas aussi bien étudiés que les macrophages dans le processus de cicatrisation, jouent en effet un rôle clé et de précédentes études ont montré que leur réponse retardée chez les patients diabétiques pouvait être un facteur majeur du retard et du délai de cicatrisation.
Oxyde nitrique vs nitrite : C'est là qu'intervient l'oxyde nitrique, une sorte de métronome chimique qui permet de relancer le processus sur le bon rythme. Mais attention, « inonder » une plaie d'oxyde nitrique n'est pas un remède miracle. « Il ne suffit pas d'appliquer et de partir, il s’agit de garder un œil sur la quantité réellement nécessaire d'oxyde nitrique ». On comprendra ici que la mesure de l’oxyde nitrique est primordiale. Or aujourd’hui, la pratique consiste à substituer la mesure du nitrite à l'oxyde nitrique mais, si les nitrites stables sont en effet plus faciles à mesurer, ils ne peuvent à eux seuls relayer l’état de cicatrisation en temps réel, au contraire des niveaux d’oxyde nitrique. Les chercheurs ont donc également développé un appareil de mesure de l'oxyde nitrique. Cela permet d’apporter à la plaie la juste quantité.
Créer un pansement à l'oxyde nitrique doté d'un pouvoir de guérison personnalisé passera encore par la collecte d’échantillons de cellules et par des essais cliniques qui permettront d’approfondir la compréhension des mécanismes induits par l’oxyde nitrique dans la cicatrisation. Mais les auteurs prévoient, d’ici quelques années seulement, un prototype de bandage fonctionnel, un prototype qui élimine l’approximation en nitrite et les décharges d’oxyde nitrique.
« Les patients souffrant d'ulcères du pied diabétique verront la lumière au bout du tunnel bien avant les 6 mois de cicatrisation aujourd’hui nécessaires », promettent les auteurs.
Autres actualités sur le même thème
ULCÈRE de JAMBE : L’exercice aussi, en combinaison avec la compression
Actualité publiée il y a 8 années 5 moisPANSEMENTS ADHÉSIFS : Et si on s’inspirait de la limace ?
Actualité publiée il y a 6 années 10 moisPLAIES et VIEILLISSEMENT CUTANÉ : Le processus qui évite la cicatrice et comble les rides
Actualité publiée il y a 9 années 1 moisANTIBIORÉSISTANCE : De toutes petites expositions suffisent
Actualité publiée il y a 7 années 11 mois




